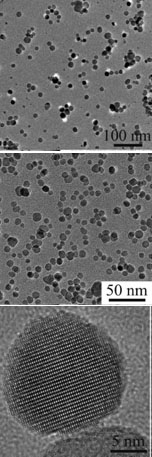

الحبيبات النانوية المغناطيسية
النانوية المغناطيسية هي فئة من الجسيمات متناهية الصغر والتى يمكن معالجتها باستخدام المجال المغناطيسي. وهذه الجزيئات تتألف عادة من العناصر المغناطيسية مثل الحديد ، النيكل و الكوبالت و المركبات الكيميائية المرتبطة بها. هذه الجسيمات قد تم التركيز عليها في الآونة الأخيرة بالكثير من الأبحاث لانها تمتلك الخصائص الجذابة التي يمكن أن نرى إمكانية استخدامها في التحفيز أو إستخدامها كعامل منشط للتفاعلات [1], الدوائيات البيولوجية [2], التصوير بالرنين المغناطيسي [3], تخزين البيانات [4] و المعالجة البيئية [5].
| "إنتل وجامعة كارنيجي ميلون في التعاون من أجل تحسين
تكاليف الطاقة والكفاءة في صنع الرقاقات. من بيتسبرغ جامعة كارنيجي ميلون وشركة إنتل سيكشفون عن فئة جديدة من المواد تسمى solder magnetic nanocomposites وهى يمكن أن تساعد في تبسيط عملية استخدام عمليات التعبئة والتغليف الإلكترونية للكمبيوتر . وسوف يكون حجر الزاوية في البحوث التي نوقشت في مؤتمر 18-22 يناير السنوي الحادى عشر للمغنطة والمواد المغناطيسية في فندق ماريوت واشنطن في منتجع واردمان في واشنطن العاصمة. وفريق البحث في جامعة كارنيجي ميلون بقيادة مايكل ماكهنري ، أستاذ علوم وهندسة المواد ، الهندسسة الطبية ، والفيزياء ، وذلك بالتعاون مع رجا سواميناثان كبير مهندسى مواد التعبئة والتغليف في إنتل ,وقد طور تقنية للتسخين بواسطة الموجات اللاسلكية (موجات الراديو) تستخدم في لحام الجسيمات متناهية الصغر المغناطيسية (MNP) وهى مركبات يمكنها أن تبعث الحرارة بما فيه الكفاية للتسبب في الإنصهار دون وضع رقائق الكمبيوتر في الأفران التقليدية. مما يؤدى إلى لحام المعادن أو السبائك معا. ويضم فريق ماكهنري:دكتوراه في مواد العلوم والهندسة المرشحين هم AshFague حبيب وكيلسي ميلر ، ومات Ondeck ، وهو أعضاء في مواد العلوم والهندسة. في الوقت الحاضر ،فإن أحدث تقنيات العصر لصناعة رقائق الكمبيوتر أثناء عملية التعبئة والتغليف الالكترونية تنطوي على الإستخدام الحراري للهواء الساخن أو إستخدام أفران الأشعة تحت الحمراء. لأن تسخين الرقائق في هذه الأفران يتطلب تكاليف كبيرة للطاقة وأيضا ينطوي على خطر warpage الرقاقات ، فريق عمل ماكهنري بالتعاون مع شركة إنتل سواميناثان لتطوير أداة لإستخدام ملفات الترددات اللاسلكية المصممة خصيصا لإحداث الحرارة في الجزيئات المغناطيسية التي تكون مختلطة مع العجائن الخاصة باللحام. "بواسطة تغيير درجات تركيز وتكوين هذه الجزيئات المغناطيسية نتمكن من السيطرة على الوقت الذي نستغرقه لتسخين تلك الجزئيات ، مما يؤدي في النهاية إلى المساعدة على تحسين سرعة تجهيزها ، ويحتمل أن يقلل من تكلفة" ، ويقول ماكهنري ، والمشارك في منصب ناشر مساعد لمجلة مؤتمر MMM / Intermag . المؤتمر السنوي يجمع العلماء والمهندسين المهتمين في التطورات الأخيرة في جميع فروع المغناطيسية الأساسية والتطبيقية. الرئيسية يتم التركيز على البحوث التجريبية والنظرية في المغناطيسية ، وتحليل الخصائص المغناطيسية للمواد الجديدة ، والتقدم في التكنولوجيا المغناطيسية. هو دائما يسعدنا أن نرى فكرة أثبتت فعلا في الواقع ، قال "سواميناثان ان" هذا اول عرض ناجح يمكن أن يفتح آفاقا جديدة من التطبيقات الأخرى حتى خارج تعبئة المكونات الإليكترونية الميكروية microelectronic. على الرغم من اننا امامنا طريق طويل لنقطعه في تنفيذ لحام موضعى إنصهارى في التطبيقات الفعلية ، ومفهوم التدفئة المحلية يفتح فرصا عديدة لفرص اتجهيز من أننا نعمل على مواصلة الإستكشاف مع ماكهنري. قال سواميناثان هناك فرصة كبيرة هنا للاطلاع على العلوم الأساسية جيدة واستكشاف التكنولوجيا "، . بالإضافة إلى تسريع عملية اللحام ،فإن فريق ماكهنري أيضا قد أسهم في تحسين الوصلات الكهربائية خلال فترة حرجة لعملية التعبئة الإلكترونية. لأن warpage الرقاقات هو أكثر من مشكلة عند درجات الحرارة المطلوبة لجعل لحام reflow خال من الرصاص ، هذه التكنولوجيا المتقدمة المطورة من قبل الباحثين كارنيجي ميلون ستكون لها فوائد إضافية مع عمليات اللحام الأكثر ملاءمة للبيئة قال ماكهنري "هناك الكثير من الاحتمالات لهذه العملية عبر مجموعة متنوعة من قطاعات الصناعة ، بما في ذلك قطاع شبه الموصلات ، والفضاء وصناعة وتخزين البيانات ،" . بحث تمويل لهذا المشروع يأتي من رقعة واسعة من المصادر ، بما في ذلك صنع رقاقات شركة انتل العملاقة ومؤسسة العلوم الوطنية. " |
الخواص
الخصائص الفيزيائية والكيميائية للنانوية المغناطيسية تعتمد إلى حد كبير على طريقة التوليف والتركيب الكيميائي. في معظم الحالات ، والجسيمات تتراوح من 1 إلى 100 نانومتر في الحجم ويمكن أن تعرض صفات superparamagnetism. [6]
Synthesis
The established methods of magnetic nanoparticle synthesis include:
Co-precipitation
Co-precipitation is a facile and convenient way to synthesize iron oxides (either Fe3O4 or γ-Fe2O3) from aqueous Fe2+/Fe3+ salt solutions by the addition of a base under inert atmosphere at room temperature or at elevated temperature. The size, shape, and composition of the magnetic nanoparticles very much depends on the type of salts used (e.g.chlorides, sulfates, nitrates), the Fe2+/Fe3+ ratio, the reaction temperature, the pH value and ionic strength of the media.[6]
Thermal decomposition
Monodisperse magnetic nanocrystals with smaller size can essentially be synthesized through the thermal decomposition of organometallic compounds in high-boiling organic solvents containing stabilizing surfactants [6].
Microemulsion
Using the microemulsion technique, metallic cobalt, cobalt/platinum alloys, and gold-coated cobalt/platinum nanoparticles have been synthesized in reverse micelles of cetyltrimethlyammonium bromide, using 1-butanol as the cosurfactant and octane as the oil phase. [6]
Applications
A wide variety of applications have been envisaged for this class of particles these include:
Medical Diagnostics and Treatments
Magnetic nanoparticles are used in an experimental cancer treatment called magnetic hyperthermia in which the fact that nanoparticles heat when they are placed in an alternative magnetic field is used.
Another potential treatment of cancer includes attaching magnetic nanoparticles to free-floating cancer cells, allowing them to be captured and carried out of the body. The treatment has been tested in the laboratory on mice and will be looked at in survival studies.[7][8]
Magnetic immunoassay
Magnetic immunoassay[9] (MIA) is a novel type of diagnostic immunoassay utilizing magnetic beads as labels in lieu of conventional, enzymes , radioisotopes or fluorescent moieties.
المصادر
- ^ A.-H. Lu, W. Schmidt, N. Matoussevitch, H. Bönnemann, B. Spliethoff, B. Tesche, E. Bill, W. Kiefer, F. Schüth (2004). "Nanoengineering of a Magnetically Separable Hydrogenation Catalyst". Angewandte Chemie International Edition. 43 (33): 4303–4306. doi:10.1002/anie.200454222.
{{cite journal}}: Unknown parameter|month=ignored (help)CS1 maint: multiple names: authors list (link) - ^
A. K. Gupta, M. Gupta (2005). "Synthesis and surface engineering of iron oxide nanoparticles for biomedical applications". Biomaterials. 26 (18): 3995–4021. doi:10.1016/j.biomaterials.2004.10.012.
{{cite journal}}: Unknown parameter|month=ignored (help) - ^ S. Mornet, S. Vasseur, F. Grasset, P. Verveka, G. Goglio, A. Demourgues, J. Portier, E. Pollert, E. Duguet, Prog. Solid StateChem. 2006, 34, 237.
- ^ T. Hyeon, Chem. Commun. 2003, 927
- ^ D. W. Elliott, W.-X. Zhang, Environ. Sci. Technol. 2001, 35, 4922.
- ^ أ ب ت ث A.-H. Lu, E. L. Salabas and F. Schüth, Angew. Chem., Int. Ed., 2007, 46,1222–1244
- ^ Scarberry KE, Dickerson EB, McDonald JF, Zhang ZJ (2008). "Magnetic Nanoparticle-Peptide Conjugates for in Vitro and in Vivo Targeting and Extraction of Cancer Cells". Journal of the American Chemical Society. 130: 10258–62. doi:10.1021/ja801969b. PMID 18611005.
{{cite journal}}: Cite has empty unknown parameter:|1=(help); Unknown parameter|month=ignored (help)CS1 maint: multiple names: authors list (link) - ^ Using Magnetic Nanoparticles to Combat Cancer Newswise, Retrieved on July 17, 2008.
- ^ Magnetic immunoassays: A new paradigm in POCT IVDt, July/August 2008.